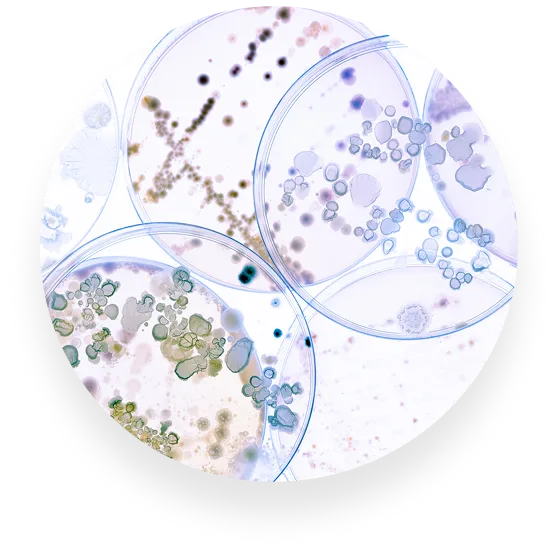
Immuno-LP20™

"My Knees and Skin, YAY! I have not been taking HydraFlex for a long time but I had to reorder it because I can already see a difference! I walk 1 mile every other day. My knees are terrible but they stopped hurting while I'm walking! And my face looks dewy soft! I also think this is helping to diminish my turkey neck!"
HydraFlex
A once-daily capsule designed to flood your skin (and joints!) with deep, lasting, hydration from within. For smoother, plumper, and more radiant-looking skin, and healthy joints, from head to toe.
Choose Options:
-

1 Bottle
Placeholder -

3 Bottles
MOST POPULAR -

6 Bottles
BEST VALUE




"My Knees and Skin, YAY! I have not been taking HydraFlex for a long time but I had to reorder it because I can already see a difference! I walk 1 mile every other day. My knees are terrible but they stopped hurting while I'm walking! And my face looks dewy soft! I also think this is helping to diminish my turkey neck!"
"HydraFlex is an excellent product. It allows my skin to feel moist and hydrated. My skin just beams! Thank you so much for this product."

Laurie Knight
Verified Buyer
1-Year Money-Back Purchase Protection
Dry Skin and/or Stiff Joints?

Everyone talks about collagen - but if your skin feels dry, papery, or tight… and if your joints sometimes feel achy… the real issue is probably hydration.
Specifically, your cells aren’t holding moisture like they used to.
It’s not your fault. It’s not about drinking more water. It all comes down to your body’s natural hydration system.
When you’re younger, your skin and joints naturally produces (and maintain!) the different molecules they needs to store and protect moisture.
But with age, that system breaks down. Moisture starts leaking out of your skin faster than you can replace it. And joints often “dry out,” with activity, leading to aches and pains.
Moisturizing creams and lotions help cover up skin problems, but they don’t solve it. Same with anti-inflammatories for the joints.
That’s why we created HydraFlex: for truly radiant plump skin that glows from within, and healthy, lubricated joints.
"From Day 1 I saw results and improvement with my knee joints. I have had left meniscus surgery and my perone sometimes slightly pops out of my right knee joint - but I always managed to put it right back - but it has bothered me for years. Since taking your supplement, not once have I had a popping incident with my right perone again AND both knee joints are doing very well! I started back with yoga although I do avoid sitting back on both my knees. Swimming is great as well and Long Beach walks are hard on my knees any longer! I do not miss a single day of taking my supplement! Thank you Sun Coast Sciences!"

Maria de Alvare, M.D.
Verified Buyer
HydraFlex
Once A Day For Deep, Lasting Hydration

It’s a doctor-designed formula to restore the health of your skin’s natural moisture lock system… so your skin can hold and protect moisture like it used to.
Take it daily to smooth out fine lines, soften rough patches, and restore that plump, bouncy glow.

Liposomal Hyaluronic Acid
And for maximum potency, our hyaluronic acid is wrapped in a special liposomal layer. That helps protect it from stomach acid, so more of it reaches your skin cells intact.
In a clinical study, this form of HA boosted elasticity by 37.5% … in just a few short weeks. In another study, people experienced a 55% reduction in knee discomfort with hyaluronic acid supplementation!

Immuno-LP20™
It compels your gut to broadcast “produce more hyaluronic acid” signals, out to your skin and joints… just like it did when you were younger. In a recent placebo-controlled study, participants using Immuno-LP20™ showed a 17.7% boost in facial hydration, and a 33.5% increase on their forearms.

MSM
MSM also supports collagen and keratin production, for firmer, smoother skin all over the body, and improved joint health.
When paired with the two ingredients above, it completes the trio, so your skin and joints can hydrate and hold onto moisture longer.

Liposomal Hyaluronic Acid
And for maximum potency, our hyaluronic acid is wrapped in a special liposomal layer. That helps protect it from stomach acid, so more of it reaches your skin cells intact.
In a clinical study, this form of HA boosted elasticity by 37.5% … in just a few short weeks. In another study, people experienced a 55% reduction in knee discomfort with hyaluronic acid supplementation!
Immuno-LP20™
It compels your gut to broadcast “produce more hyaluronic acid” signals, out to your skin and joints… just like it did when you were younger. In a recent placebo-controlled study, participants using Immuno-LP20™ showed a 17.7% boost in facial hydration, and a 33.5% increase on their forearms.

MSM
MSM also supports collagen and keratin production, for firmer, smoother skin all over the body, and improved joint health.
When paired with the two ingredients above, it completes the trio, so your skin and joints can hydrate and hold onto moisture longer.
1-Year Money-Back Purchase Protection
"It really works! A few months ago I noticed the skin on my arms was wrinkled-much to my horror! I started taking HydraFlex and happily am noticing my skin firming and glowing from the inside out!! And not just my arms but everywhere! My face is glowing and firming as well. It’s like I’m aging backwards! I love it. BTW, I’m 65 years old."

Joan Heitzler
Verified Buyer
How To Use It
(Hint: HydraFlex pairs perfectly with Total Package Serum, Total Night Cream and our Hydrate + Restore Face Wash, for the ultimate defense against sagging skin.)
Just wash it down with a sip of water and let its elastase-blocking, skin-lifting superpowers go to work on every inch of skin on your body.
And yes — you’re welcome (and encouraged) to double up your serving, especially in the first few months. Consider it your “kickstart” serving of HydraFlex to halt the look of sagging skin faster than ever.


How To Use It
(Hint: HydraFlex pairs perfectly with Total Package Serum, Total Night Cream and our Hydrate + Restore Face Wash, for the ultimate defense against sagging skin.)
Just wash it down with a sip of water and let its elastase-blocking, skin-lifting superpowers go to work on every inch of skin on your body.
And yes — you’re welcome (and encouraged) to double up your serving, especially in the first few months. Consider it your “kickstart” serving of HydraFlex to halt the look of sagging skin faster than ever.
Perfect For...

Dry, Crepey, or Rough Skin

More Plump and Dewey Glow

Healthy Joints & Mobility
What to Expect...
While everyone’s results will vary, here’s a common timeline for many HydraFlex customers:
Day 14

Hydration pathways begin reactivating, and the difference starts to show. Skin feels softer, less tight, and dry patches begin to smooth out. That “parched” feeling starts to fade. Many customers also report their joints feel more fluid: less stiff in the morning, and more comfortable through the day.
Day 30

Moisture holds longer through the day… no more dryness by afternoon. Fine lines smooth more, and radiance improves. Joint aches begin to ease, wrists and knees feel looser, and daily movements become smoother and easier.
Day 60

Bigger shifts in skin texture and elasticity. Arms and legs feel smoother. Knees and elbows look more supple. Your face reflects a deeper, more lasting hydration, without needing layers of cream. Joint mobility continues to improve, especially in high-use areas like hips, shoulders, and neck. Many users say they feel “lighter” or more active throughout the day.
Day 90

More dramatic improvements in firmness, glow, and all-day hydration. Crepey skin on the arms, chest, and neck appears visibly smoother. Makeup goes on better. Compliments pick up. Joint stiffness becomes far less noticeable, especially in the mornings. Some users report increased activity levels or even resuming light exercise routines they had put off due to discomfort.

Beyond
With daily use, your skin stays hydrated, plump, and resilient, looking healthy and radiant, even as the years go by. Your joints stay cushioned and flexible, helping you move more easily, feel more confident, and stay active with less effort.
Try HydraFlex With Confidence

Targets The Root Cause of Dry Skin
HydraFlex is the first product that reactivates the natural moisture lock functions in your skin and joints… so they can finally absorb and seal in moisture like they used to. With clinically backed ingredients like liposomal hyaluronic acid and Immuno-LP20™, it works from the inside out to smooth rough patches, plump fine lines, and restore lasting hydration.

Made in The USA
HydraFlex is manufactured at a CGMP facility, just outside of Salt Lake City, Utah, using domestically and internationally sourced ingredients. Every batch is DNA-tested for purity and potency, so you can rest assured that what’s on the label is what’s in the bottle.

1 Year of Purchase Protection
Whether you buy one bottle or many, one-time or subscription, you’re protected by our 1 year guarantee. Use up your entire order, and if you don’t love it, simply return your empty bottles for a full refund of your purchase price. We make it easy and hassle-free, over phone, email or your customer account.

Quick Shipping
HydraFlex orders are packed daily, Monday through Friday and shipped the following business day. Most shipments arrive within 5-7 days of your order. Shipping estimates can be found on checkout.

Designed by Dr. Mark Rosenberg
HydraFlex was born from Dr. Rosenberg’s anti-aging research, on why cells “go bad,” and what can be done to reverse this process. It’s a signature formula, with unique ingredients, crafted by one of America’s top anti-aging experts.

Targets The Root Cause of Dry Skin
HydraFlex is the first product that reactivates the natural moisture lock functions in your skin and joints… so they can finally absorb and seal in moisture like they used to. With clinically backed ingredients like liposomal hyaluronic acid and Immuno-LP20™, it works from the inside out to smooth rough patches, plump fine lines, and restore lasting hydration.

Made in The USA
HydraFlex is manufactured at a CGMP facility, just outside of Salt Lake City, Utah, using domestically and internationally sourced ingredients. Every batch is DNA-tested for purity and potency, so you can rest assured that what’s on the label is what’s in the bottle.

1 Year of Purchase Protection
Whether you buy one bottle or many, one-time or subscription, you’re protected by our 1 year guarantee. Use up your entire order, and if you don’t love it, simply return your empty bottles for a full refund of your purchase price. We make it easy and hassle-free, over phone, email or your customer account.

Quick Shipping
HydraFlex orders are packed daily, Monday through Friday and shipped the following business day. Most shipments arrive within 5-7 days of your order. Shipping estimates can be found on checkout.

Designed by Dr. Mark Rosenberg
HydraFlex was born from Dr. Rosenberg’s anti-aging research, on why cells “go bad,” and what can be done to reverse this process. It’s a signature formula, with unique ingredients, crafted by one of America’s top anti-aging experts.

Dr. Rosenberg on HydraFlex
“I created HydraFlex because so many women came to me saying the same thing: ‘My skin still feels dry, no matter what I try.’
After years of research, I discovered that most skincare routines ignore the actual problem: your skin’s hydration system has broken down. It’s not just about drinking water or applying lotion. It’s about reactivating the natural moisture system that’s already in your skin.
HydraFlex is the first and only formula to do this, and it works from the inside out. It’s changed the way my patients think about skincare, and it’s the first product I recommend to anyone struggling with dryness, crepey skin, or tightness that just won’t go away.
But what surprised many of my patients was how much it helped with their joints, too. Because the same ingredient that hydrates your skin - hyaluronic acid - also cushions and lubricates your joints. So while HydraFlex was designed to make your skin look younger, it also helps your body move more easily, with less stiffness.
That’s why I recommend HydraFlex not just for dry, crepey skin, but for anyone who wants to feel better in their body, inside and out.”
Dr. Mark Rosenberg, M.D.
Radiant Customers Around The World

Frequently
Asked Questions
It's sure strange they called it an acid - more appropriate would be something like "water sponge." This ingredient sucks up moisture in the air and in your body, and delivers it where it's so needed - your skin, and your joints.


















